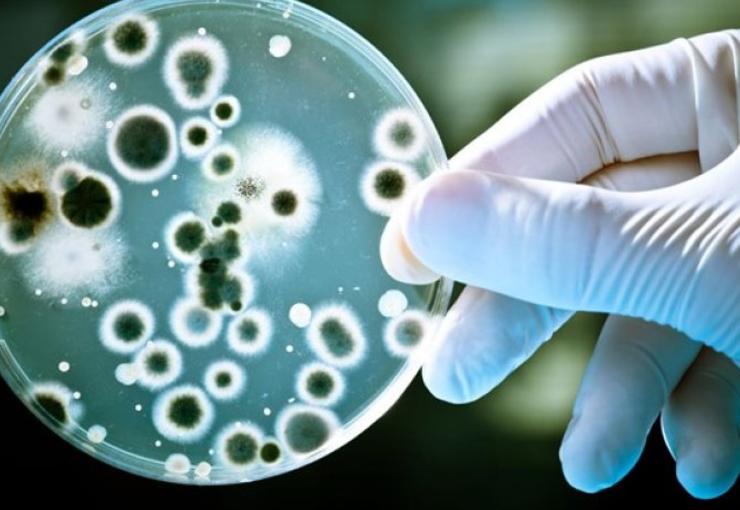

Çin’de bu defa 'brusella bakterisi' salgını paniği
Corona virüs salgınının ardından Çin'de şimdi de yeni bir salgın başgösterdi.
Olay Çin'in Lanzhou kentinde meydana geldi. Brusella bakterisine karşı aşı üreten ilaç firmasının ihmalkarlığı salgına yol açtı.
Kentin sağlık yetkililerine göre, aşı üretimi sırasında, buhar emisyonlarının yanlış ve hatalı sterilizasyonu bakterinin yayılmasına yol açtı.
Bakterinin koyun, sığır ve domuzlar aracılığıyla 3 bin 245 kişiye bulaştığı belirtiliyor. Yetkililer, hastalara ekim ayından itibaren tazminat ödeyeceklerini duyurdu.
Brusella hastalığı baş ve kas ağrısı, ateş, yorgunluk gibi semptomlara neden olabiliyor.
GERÇEK GÜNDEM
Yorum Ekle
Diğer Haberler
İngiltere Championship'te ayın golü, Okay Yokuşlu'dan
West Bromwich Albion forması giyen milli futbolcu Okay Yokuşlu'nun Huddersfield ağlarına gönderdiği gol, İngiltere Championship'te mart ayının en iyi golü seçildi.
ABD'de polis üniversitelere saldırıyor, Netanyahu daha fazlasını istiyor
ABD’de ülke genelinde üniversite kampüslerine yayılan İsrail’e karşı Filistin’e destek eylemleri devam ediyor. Birçok üniversitenin kampüsünde öğrenciler nöbet çadırları kurdu, insan zinc...
Tanzanya'da sel felaketi! Can kaybı artıyor...
Başkent Nairobi ve diğer büyük kentlerin büyük bir bölümü sular altında kalırken, binlerce kişi evlerini terk etti. Ülke genelinde devam eden sel nedeniyle can kaybının artmasının beklend...
Karabağ'daki Türk-Rus Ortak Merkezi görevini tamamladı
Merkezin görevini tamamlaması dolayısıyla düzenlenen törene Azerbaycan Genelkurmay Başkanı Korgeneral Kerim Veliyev, Rusya Genelkurmay Başkan Yardımcısı Korgeneral Sergey İstrakov, Türk K...
'Çin casusu' krizi: Elçi bakanlığa çağrıldı
Büyükelçi Flor, X sosyal medya hesabından yaptığı açıklamada, 4 Alman vatandaşının casusluk suçlamasıyla gözaltına alınması sonrası Çin Dışişleri Bakanlığınca çağrıldığını duyurdu. Flor, ...
Türkiye’den AB’ye Kıbrıs tavrı
Avrupa Birliği’nin (AB) son zirvesinde ilişkilerin geleceğine yönelik alınan kararlardan rahatsızlığını gizlemeyen Türkiye, tepkisini nokta atışlarıyla pratikte de göstermeye başladı. Tür...
Kral Charles, tartışmalı göçmen planını onayladı
İngiltere Kralı 3. Charles, düzensiz göçmenlerin Ruanda'ya sınır dışı edilmesine ilişkin tasarıyı onayladı. Kraliyet Sözcüsü, Ruanda Planı'nın Kral 3. Charles'ın onayıyla yasalaştığını d...
ABD'den dikkat çeken hamle! USS George Washington Japonya'ya gidiyor...
Çin ve Rusya'nın Hint-Pasifik bölgesinde nüfuzunu artırması karşısında müttefiki Japonya ile askeri işbirliğini güçlendiren ABD’den kritik bir hamle geldi.
Dışişleri Bakanlığı'ndan sert tepki: ''Yok hükmünde''
Dışişleri Bakanlığı tarafından yapılan açıklamada, "Şili Temsilciler Meclisi tarafından dün (24 Nisan) kabul edilen ve 1915 olaylarını 'soykırım' olarak tanıyan kararı yok hükmündedir. Pa...
SOSYAL MEDYA
MAGAZİN
Kerem Bürsin'in paylaşımı sosyal medyayı salladı
Oyuncu Kerem Bürsin'in Instagram hesabında paylaştığı kaslı vücudu sosyal medyayı salladı. 'Şeref Meselesi', 'Güneşi Beklerken', 'Ulan İstanbul', 'Sen Çal Kapımı' ve 'Ya Çok Seversen' gib...
TEKNOLOJİ
EDİTÖR'ÜN SEÇTİKLERİ
Sıcak geçen ilkbahar kabusu erken getirdi
Hava sıcaklığının mevsim normalleri üzerinde seyretmesinden dolayı Kırım Kongo Kanamalı Ateşi (KKKA) hastalığını bulaştıran keneler doğada erken görülmeye başladı. Uzmanlar keneler konusunda vatandaşı dikkatli olmaya çağırdı...










































Yorumlar
Bu haberde yorum bulunmamaktadir.